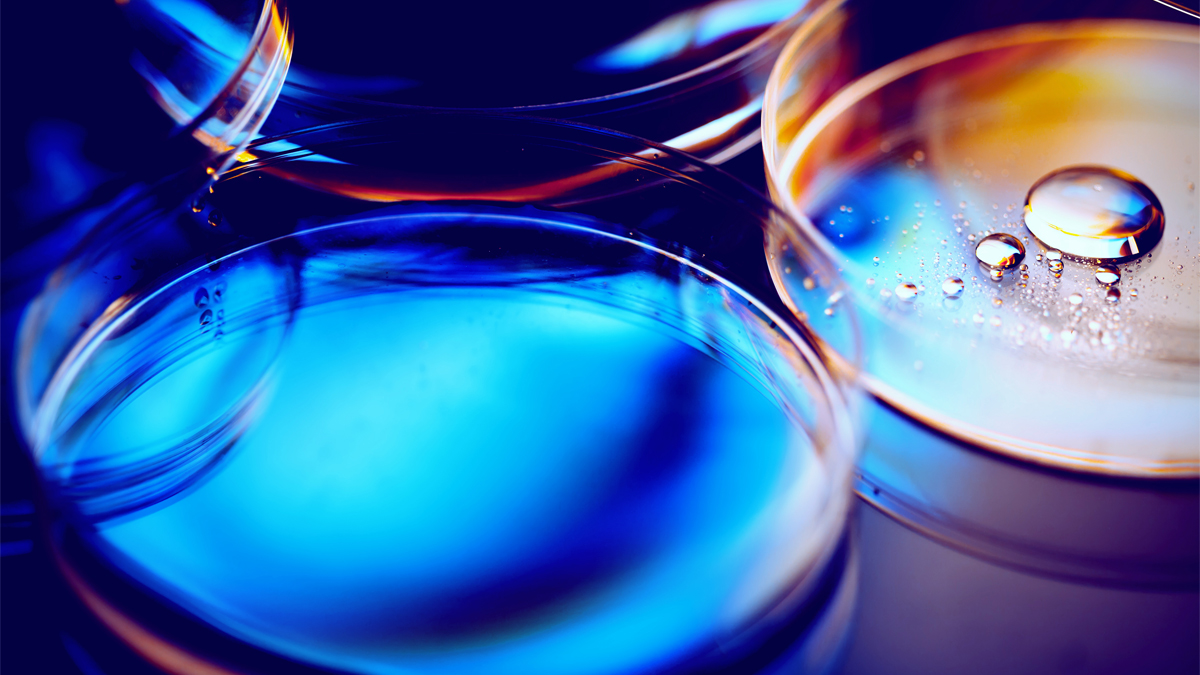

Try to imagine a dish that thinks it's a brain. If you can, you can seriously start thinking about working alongside Dr Angela Bithell.
As a an Associate Professor in Stem Cell Biology and Regenerative Medicine, her research has led to the development of 3D 'brain network' models in vitro. The in vitro models have been specially created to help us build a better understanding of central nervous system diseases and their causes. By mimicking features of healthy human brains and brains affected by Alzheimer's disease, Angela's work aims to identify and test life-changing new drugs.